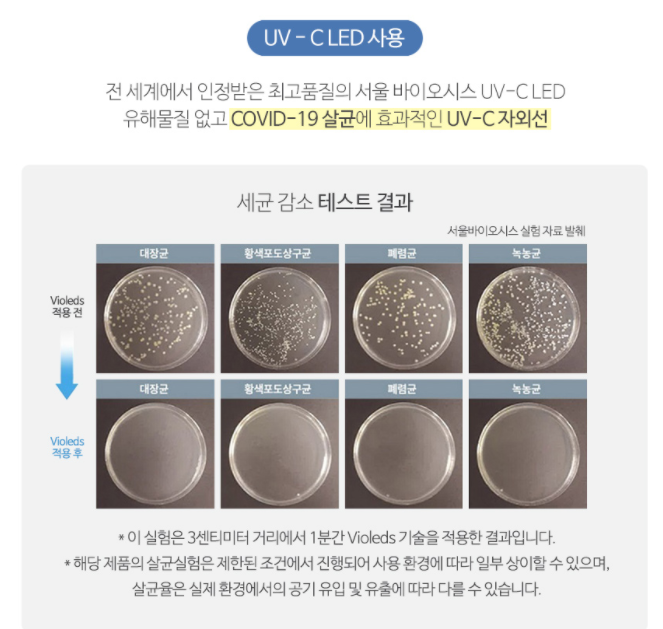

마스크살균기 MASKCARE 강력한 UVC 살균기
지하철에서 누가 옆에서 기침을하고 있으면 너무나도 신경이 쓰이는데요. 그래도 다행인 게 마스크를 하고 있기 때문에 안심은 됩니다. 개인 위생에 마스크가 중요한데 마스크 역시 세균, 바이러스에 노출되어 있어 관리가 필요합니다.
마스크 전용 살균기 MASKCARE를 사용하면서 어떤 제품인지 알려드리려고 합니다. 마스크는 매일 사용하고 매일 새것으로 쓰면 좋지만, 가격적인 부담과 잠시 사용후 살균도 필요하기 때문에 마스크살균기가 필요하였습니다.


마스크살균기 MASKCARE은 중국산이 아닙니다. 국내 생산 제품으로 세계적으로 UVC LED 제조업체로 유명한 서울바이오시스의 VIOLEDS UVC LED를 사용하고 있습니다.
오랜시간 사용이 가능하고 강력한 살균력으로 마스크 전용 살균이 가능합니다.
마스크 살균기 추천 MASKCARE 국내 UVC살균램프

마스크살균기 MASKCARE은 마스크가 들어갈 수 있는 긴 원통형으로 생겼습니다.


패키지는 깔끔하게 제품 설명과 함께 QR코드로 카카오 플러스친구를 제공합니다.


마스크살균기 MASKCARE에 대한 주의사항이 있습니다. 하단에 스위치를 켜고 써야 하니깐 까먹지 말라고 되어 잇고 하단에 센서렌즈와 살균 자외선은 청결하게 관리해달라고 합니다.
딱히 어려운 것이 없습니다.


하단에 스위치를 켜주면 됩니다.


마스크살균기 MASKCARE에 마스를 넣고 뚜껑을 덮으면 자동 센스가 동작합니다. 또는 측면 수동 버튼을 눌러 동작시킬 수 있습니다.
집에 마스크 살균기가 다른 제품도 있는데, 살균박스는 다용도로 사용할 수 있는 제품이였거든요. 하지만 마스크살균기 MASKCARE은 마스크가 전체적인 면이 직접 UVC살균 램프가 닿게 설계되어 있어 강력하고 정확한 살균을 기대할 수 있겠다는 생각이 들었습니다.
그래서 집에 오면 마스크 살균은 마스크살균기 MASKCARE에게 시키고 있습니다.


뚜껑을 닿으면 살균을 진행합니다.


충전식이라 내장 배터리로 충전선 없이 계속 하용할 수 있다는 것이 좋습니다. 다른 제품은 충전식이 아니라서 원하는 곳에 두고 쓸 수 없거든요.
마스크살균기 MASKCARE는 2600mAh의 배터리가 있어 좋습니다. 3분만에 살균이 됩니다.


100% 국산 UVC살균 램프를 사용합니다. 유명한 서울방오시스의 VIOLEDS UVC LED를 사용하고 있어 안심이 됩니다.

마스크를 자주 넣고 빼다보면 오염물이 묻을 수 있어 3단계로 분리해서 세척이 가능합니다.


마스크의 겉면에도 세균이 많다는 거 알고 계시나요?
코로나19 때문에 더욱 UVC 살균기에 관심이 많아 다양한 살균기를 사용하고 있는데요. 마스크살균기 MASKCARE 는 마스크를 위한 전용 살균이 가능하게 설계되어 있고 믿을 수 있는 국내 100% 생산 UVC 램프를 사용하고 있어 안심되는 결과지도 같이 가지고 있습니다.
3분만 투자하면 99.9% 살균의 항상 깨끗한 마스크를 쓸 수 있습니다. 무기한 향균제를 사용하여 제품에 세균 번식도 없고 깨끗한 통에 넣어 살균하게 되는 점도 마음에 드네요.
짝퉁 중국산 UVC살균 램프말고 국내산 믿을 수 있는 인증제품을 사용하실걸 권해드립니다.